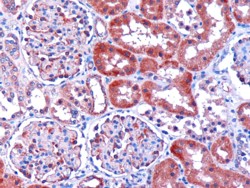

Goat Anti-Dicarbonyl Reductase Antibody
Peptide-affinity purified goat antibody
- SPECIFICATION
- CITATIONS
- PROTOCOLS
- BACKGROUND

Application
| WB, IHC, E |
|---|---|
| Primary Accession | Q7Z4W1 |
| Other Accession | NP_057370, 51181 |
| Reactivity | Human |
| Host | Goat |
| Clonality | Polyclonal |
| Concentration | 100ug/200ul |
| Isotype | IgG |
| Calculated MW | 25913 Da |
| Gene ID | 51181 |
|---|---|
| Other Names | L-xylulose reductase, XR, 1.1.1.10, Carbonyl reductase II, Dicarbonyl/L-xylulose reductase, Kidney dicarbonyl reductase, kiDCR, Short chain dehydrogenase/reductase family 20C member 1, Sperm surface protein P34H, DCXR, SDR20C1 |
| Dilution | WB~~1:1000 IHC~~1:100~500 E~~N/A |
| Format | 0.5 mg IgG/ml in Tris saline (20mM Tris pH7.3, 150mM NaCl), 0.02% sodium azide, with 0.5% bovine serum albumin |
| Storage | Maintain refrigerated at 2-8°C for up to 6 months. For long term storage store at -20°C in small aliquots to prevent freeze-thaw cycles. |
| Precautions | Goat Anti-Dicarbonyl Reductase Antibody is for research use only and not for use in diagnostic or therapeutic procedures. |
| Name | DCXR |
|---|---|
| Synonyms | SDR20C1 |
| Function | Catalyzes the NADPH-dependent reduction of several pentoses, tetroses, trioses, alpha-dicarbonyl compounds and L-xylulose. Participates in the uronate cycle of glucose metabolism. May play a role in the water absorption and cellular osmoregulation in the proximal renal tubules by producing xylitol, an osmolyte, thereby preventing osmolytic stress from occurring in the renal tubules. |
| Cellular Location | Membrane; Peripheral membrane protein. Note=Probably recruited to membranes via an interaction with phosphatidylinositol. |
| Tissue Location | Highly expressed in kidney, liver and epididymis. In the epididymis, it is mainly expressed in the proximal and distal sections of the corpus region. Weakly or not expressed in brain, lung, heart, spleen and testis. |

Thousands of laboratories across the world have published research that depended on the performance of antibodies from Abcepta to advance their research. Check out links to articles that cite our products in major peer-reviewed journals, organized by research category.
info@abcepta.com, and receive a free "I Love Antibodies" mug.
Provided below are standard protocols that you may find useful for product applications.
Background
The protein encoded by this gene acts as a homotetramer to catalyze diacetyl reductase and L-xylulose reductase reactions. The encoded protein may play a role in the uronate cycle of glucose metabolism and in the cellular osmoregulation in the proximal renal tubules. Defects in this gene are a cause of pentosuria. Two transcript variants encoding different isoforms have been found for this gene.
References
Defining the human deubiquitinating enzyme interaction landscape. Sowa ME, et al. Cell, 2009 Jul 23. PMID 19615732.
Structure/function analysis of a critical disulfide bond in the active site of L-xylulose reductase. Zhao HT, et al. Cell Mol Life Sci, 2009 May. PMID 19337691.
The SDR (short-chain dehydrogenase/reductase and related enzymes) nomenclature initiative. Persson B, et al. Chem Biol Interact, 2009 Mar 16. PMID 19027726.
Dicarbonyl/L-xylulose reductase: a potential biomarker identified by laser-capture microdissection-micro serial analysis of gene expression of human prostate adenocarcinoma. Cho-Vega JH, et al. Cancer Epidemiol Biomarkers Prev, 2007 Dec. PMID 18086765.
Suppression of renal alpha-dicarbonyl compounds generated following ureteral obstruction by kidney-specific alpha-dicarbonyl/L-xylulose reductase. Odani H, et al. Ann N Y Acad Sci, 2008 Apr. PMID 18079483.
If you have used an Abcepta product and would like to share how it has performed, please click on the "Submit Review" button and provide the requested information. Our staff will examine and post your review and contact you if needed.
If you have any additional inquiries please email technical services at tech@abcepta.com.





Foundational characteristics of cancer include proliferation, angiogenesis, migration, evasion of apoptosis, and cellular immortality. Find key markers for these cellular processes and antibodies to detect them.
The SUMOplot™ Analysis Program predicts and scores sumoylation sites in your protein. SUMOylation is a post-translational modification involved in various cellular processes, such as nuclear-cytosolic transport, transcriptional regulation, apoptosis, protein stability, response to stress, and progression through the cell cycle.
The Autophagy Receptor Motif Plotter predicts and scores autophagy receptor binding sites in your protein. Identifying proteins connected to this pathway is critical to understanding the role of autophagy in physiological as well as pathological processes such as development, differentiation, neurodegenerative diseases, stress, infection, and cancer.